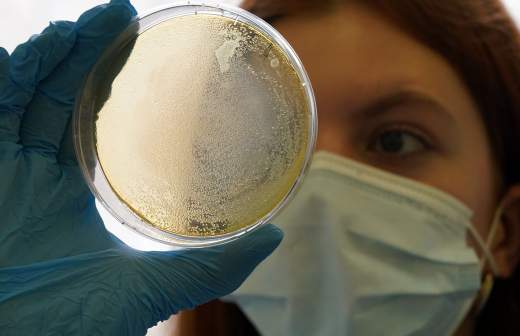

Ученые разрабатывают средство от тромбоза при COVID-19 из водорослей

В морских водорослях, распространенных на Дальнем Востоке, нашли вещества, которые могут стать основой лекарств против тромбозов — распространенного осложнения COVID-19. Ученые НИИ им. Г.П. Сомова Роспотребнадзора опубликовали статью, в которой обосновали возможность создания антикоагулянта на их основе. По словам исследователей, в будущем такой препарат может стать заменой широко используемого сейчас гепарина.
«Морские сульфатированные полисахариды могут стать важным вспомогательным терапевтическим средством при тяжелых нарушениях кроветворения, спровоцированных COVID-19, — сказал «Известиям» профессор ДВФУ, директор НИИ эпидемиологии и микробиологии им. Г.П. Сомова Роспотребнадзора Михаил Щелканов. — Они натуральны, низкотоксичны и стоят очень дешево по сравнению с синтетическими препаратами. В качестве антикоагулянтов могут представить альтернативу гепарину, наиболее распространенному антикоагулянту в медицине, который, однако, имеет негативные побочные эффекты. Полисахариды отличаются от него механизмом действия».
Пока ученые только в самом начале пути, и применение веществ из водорослей обосновано теоретически. После разработки фармсубстанции эффективность и безопасность полисахаридов еще предстоит проверить сначала на животных, а затем в полном цикле клинических испытаний.
Подробнее читайте в эксклюзивном материале «Известий»:
Приморский бой: дальневосточные водоросли победят тромбоз при COVID-19